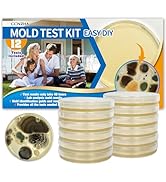

Buy anything from 5,000+ international stores. One checkout price. No surprise fees. Join 2M+ shoppers on Desertcart.
Desertcart purchases this item on your behalf and handles shipping, customs, and support to Brazil.
🕵️♂️ Detect Mold Like a Pro—Before It Detects You!
This DIY Mold Test Kit includes 12 test plates, swabs, gloves, and a detailed mold identification guide, enabling fast and reliable detection of household molds including black mold. With results in 48 hours and free expert lab analysis via photo submission, it offers a cost-effective, safe, and comprehensive solution to monitor indoor air quality and protect your home environment.

| ASIN | B0DFBVXF8G |
| Customer Reviews | 4.5 4.5 out of 5 stars (169) |
| Date First Available | 19 October 2024 |
| Item Weight | 560 g |
| Manufacturer reference | CCNZHAmold |
| Package Dimensions | 20.8 x 12.2 x 11.6 cm; 560 g |
Trustpilot
2 months ago
1 week ago